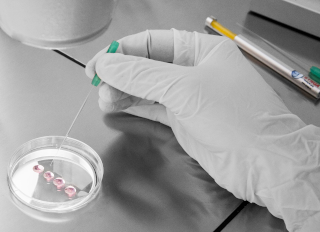
pipety

Glass Pipettes
Glass micropipettes used for denudation, and gamete and embryo handling. Manufactured from high quality borosilicate glass under cleanroom conditions.
Denuding micropipettes used for denudation, manipulation and transfer of oocytes and embryos. Each pipette is hand-made with borosilicate glass, known for its high stability and resistance to corrosion. Glass pipettes reduce the chance of oil drops attaching inside the pipette and damaging the oocyte or embryo compared to plastic pipettes.
Synga pipettes are available with polished or unpolished tip. Unpolished pipettes are ideal for denudation of the cumulus cells attached to the zona pellucida prior to micromanipulation procedures. Polished glass pipettes are ideal for transferring blastomeres, oocytes, and embryos during assisted reproductive procedures. They are also well suited for oocyte vitrification.
Product List 2025
. . . document to downloadMicromanipulation pipettes
ICSI, Holding, Biopsy and PZD pipettes, all in 30° a 35° version.. . . products
Denudation Pipettes
(sharp opening, inner diameter 130-160 µm). . . products
Manipulation Pipettes
(blunt opening, inner diameter 180 µm). . . products
Blastocyst Pipettes
(blunt opening, inner diameter 250 µm, 300 µm). . . products
Oocyte Vitrification Pipettes
(blunt opening, inner diameter 140 µm, 150 µm). . . products
Precision and quality you can trust:
- Each micropipette is handmade and individually examined
- History of each pipette, from material to technician, is controlled and tracked
- Secure packaging that is color coded for easy identification of diameter
- Mouse embryo assay tested
- Sterile - Gamma irradiated
Accessories
useful tools to support your work with Synga pipettes. . . products
